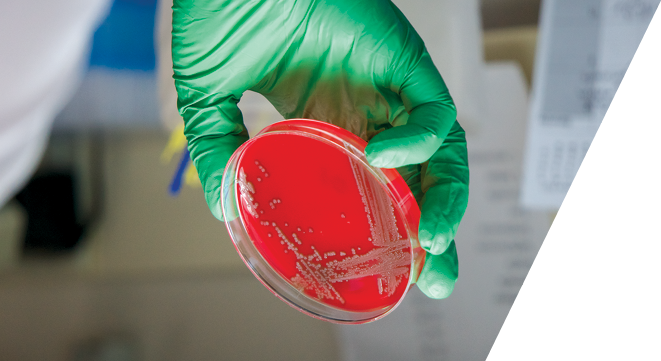

Microbiologics: A Trusted CRO Partner in Infectious Disease Research
Microbiologics is a leading Infectious Disease Contract Research Organization (CRO) who is playing a pivotal role in the development of life-saving antibiotics, antivirals, vaccines, and diagnostic technologies. The company’s consultative approach ensures close collaboration with partners, offering tailored solutions that address specific needs. With extensive experience working with a broad portfolio of BSL-2 and BSL-3 pathogens, such as SARS-CoV-2, Influenza A & B, Mycobacteria, and Chlamydia spp., Microbiologics stands out as an invaluable partner in advancing scientific research.
Cutting-Edge Antiviral Testing
Microbiologics offers a broad array of in vitro antiviral testing services. From standardized, off-the-shelf assays to fully customized, multifaceted testing programs, Microbiologics is committed to supporting pharmaceutical and academic researchers in their quest to discover novel, life-changing antiviral agents and vaccines. The company’s comprehensive antiviral testing services include: Hemagglutination Inhibition (HAI), Neuraminidase Inhibition (NAI), Microneutralization (MN), Viral Load (TCID50 and qPCR/ddPCR) and beyond, providing researchers with the reliable and actionable data they need.
Advanced Antibacterial and Antifungal Testing
Microbiologics’ Antimicrobial and Microbiome Research Center maintains a biobank of over 12,000 clinical pathogens, including strains with characterized resistance, which is available for extensive screening. Their experienced team of scientists provides high-throughput screening and susceptibility testing, lead characterization studies, test method development and evaluation, and consulting for IND/NDA submission.
They also have specialized expertise in cell-based anti-infective assays including Intracellular Killing, MTT Toxicity, and MIC testing of Chlamydia spp. Microbiologics recently expanded their capabilities to offer OPKA and SBA assays, supporting vaccine development for bacterial and fungal targets. Additional services that support the development of microbiome products and therapeutics include LBP characterization, enumeration, antibiogram analysis, evaluation of pre- and probiotics on growth kinetics of indicator organisms in co-culture, and metagenomics.
Reliable Viral and Microbial RUO Stocks
Beyond testing, Microbiologics offers the highest quality viral and microbial research-use-only (RUO) stocks, available in both live and inactivated formats, that support applications in drug development, diagnostic assay development, and academic research. They also provide extensive custom virus and microbial stock manufacturing, ensuring partners receive materials optimized for their unique research needs.
Their custom virus manufacturing services include options for host cell selection, titration, purification, and, if required, genetic modification through reverse genetics. In microbial manufacturing, they offer a range of solutions for bacteria, fungi, and phage, alongside nucleic acid formats like gDNA and RNA, providing essential materials for diagnostic and pathogen detection applications.
Partnering for a Safer, Healthier Future
Microbiologics’ commitment to customer collaboration, quality, and innovation makes them a valued partner in infectious disease research. By staying at the forefront of scientific and technological advancements, they anticipate partner needs and deliver high-quality, reproducible results that drive forward critical infectious disease solutions. With a consultative approach, their experienced team works alongside partners to overcome research challenges and meet precise project requirements, helping pave the way toward a safer, healthier future.